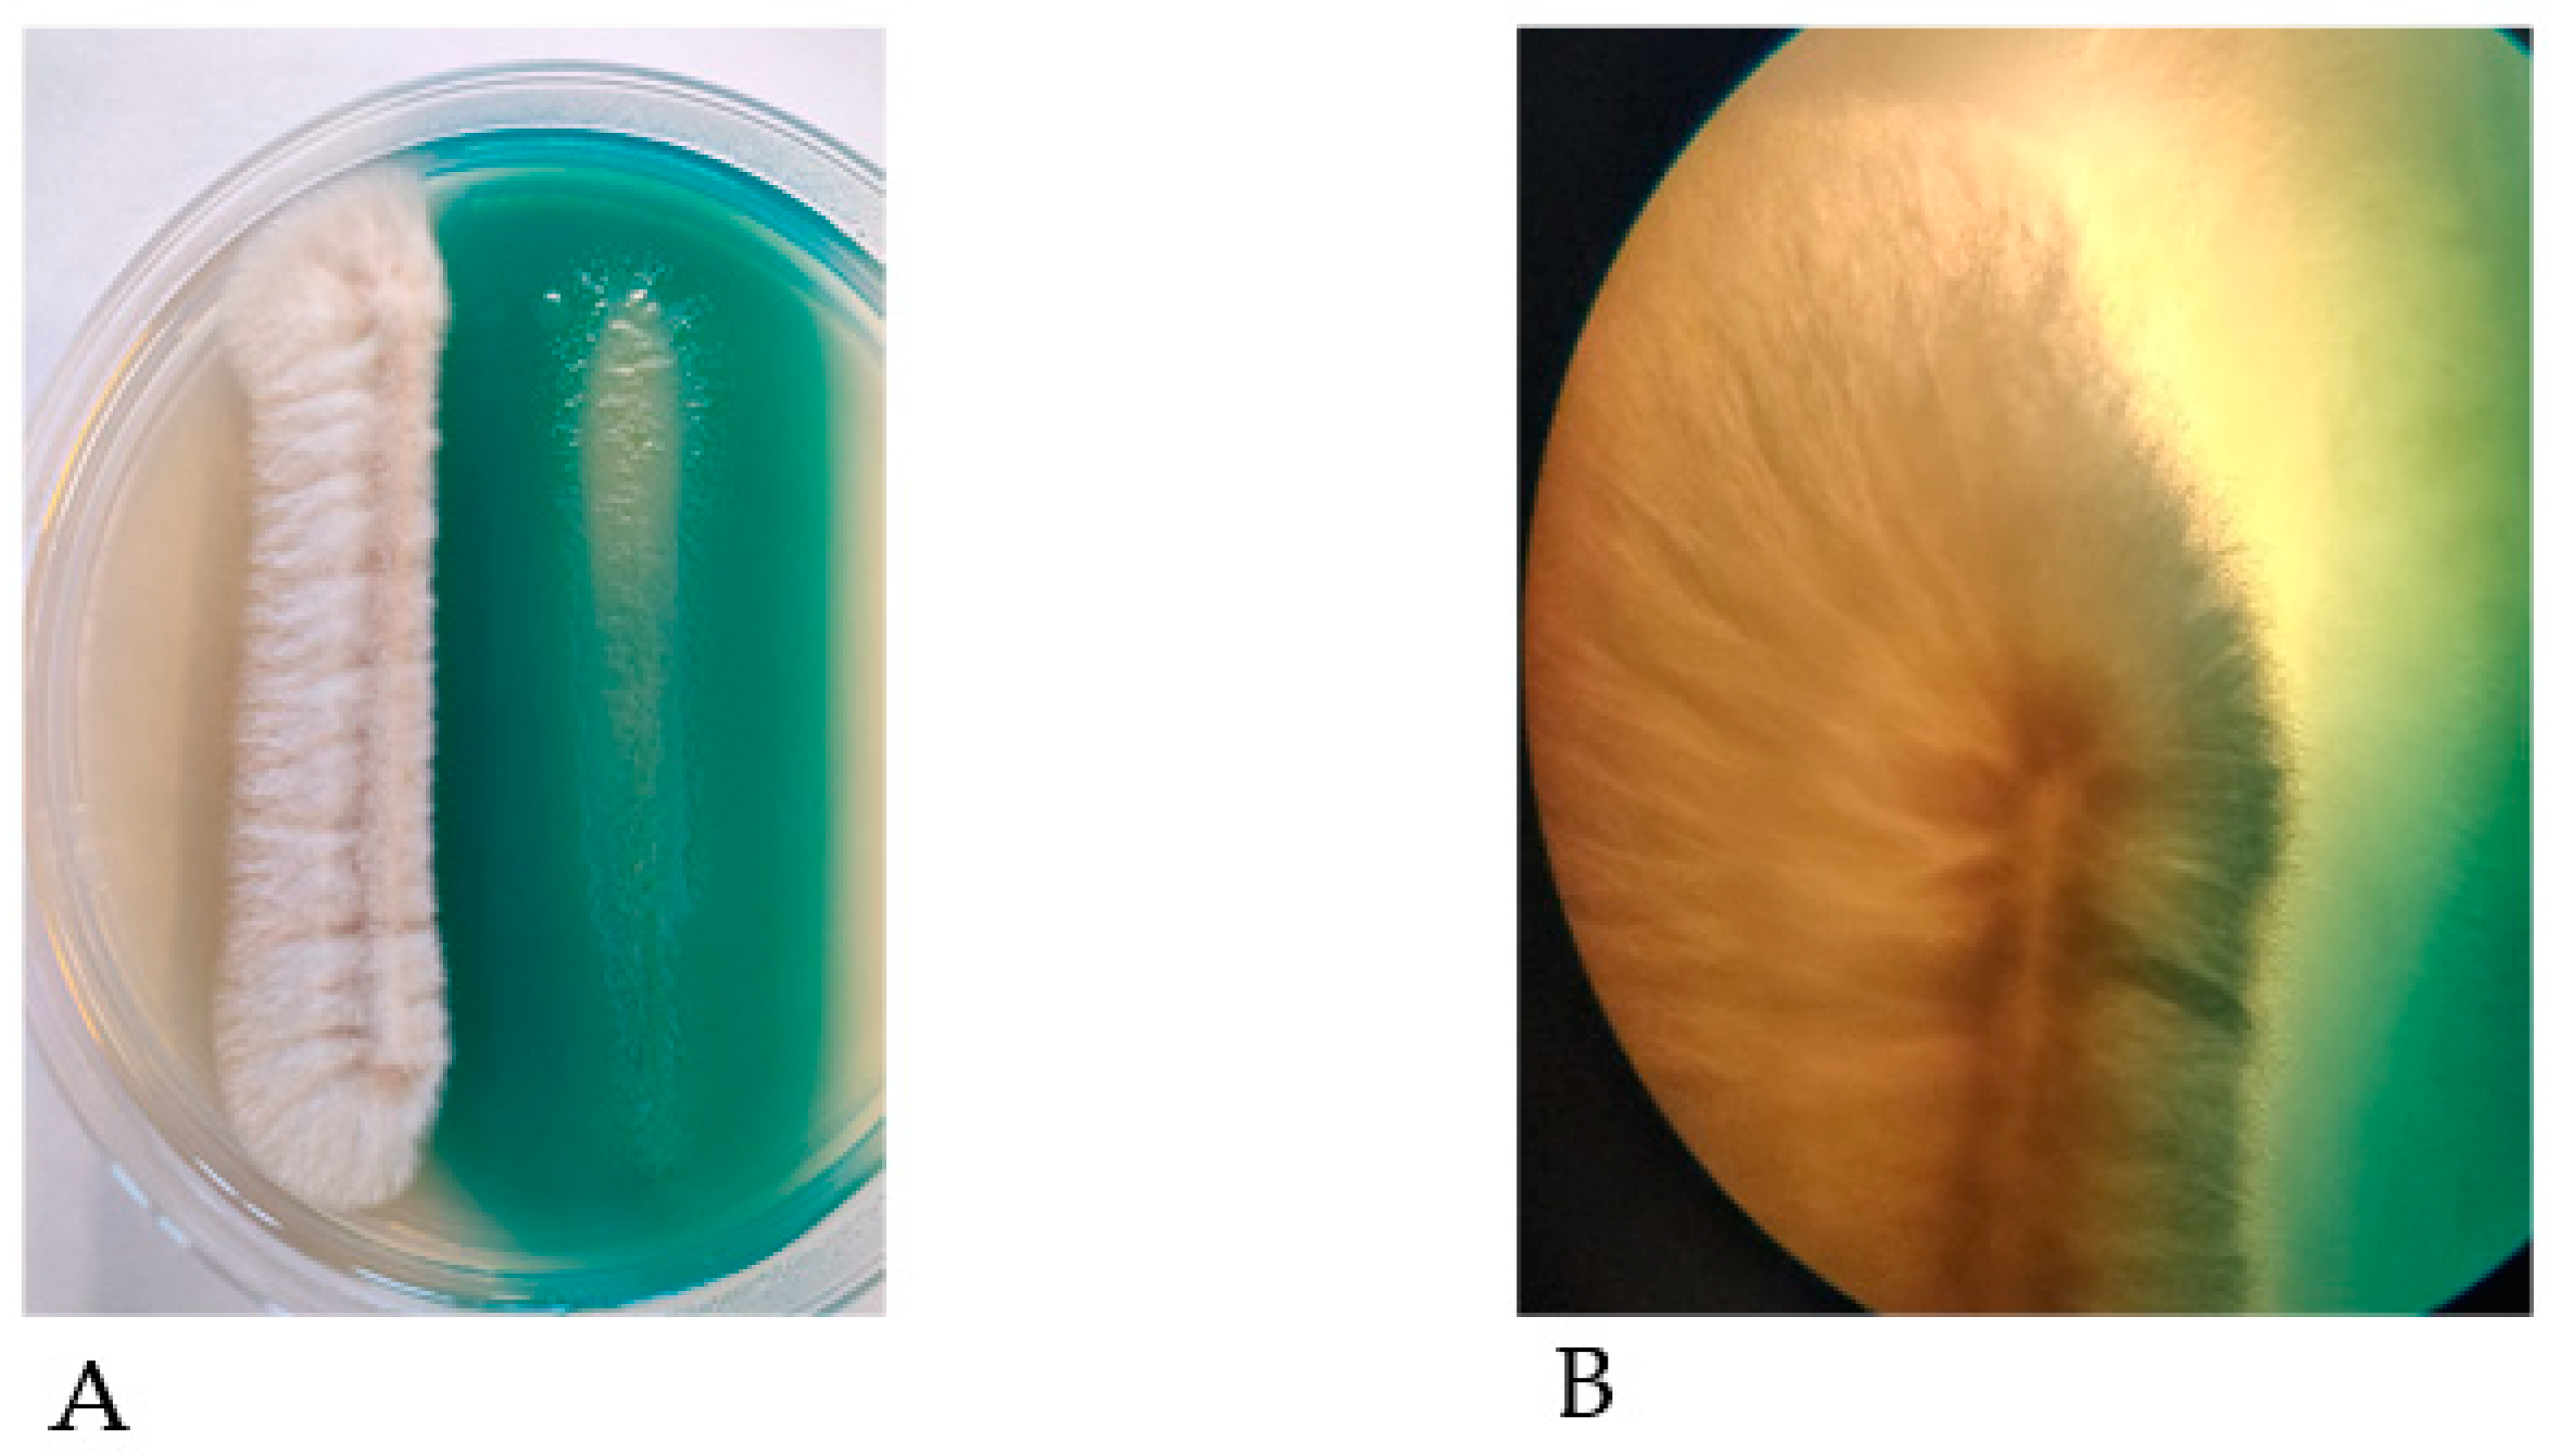
Microorganisms 09 00435 g001 Microorganisms 09 00435 g001

Bacterial Interactions with Aspergillus fumigatus in the Immunocompromised Lung
Abstract
1. Introduction
2. Aspergillus fumigatus
3. Pseudomonas aeruginosa
4. The Microbial Environment of the Immunocompromised Airways
5. The Interactions Between A. fumigatus and P. aeruginosa
6. Interactions Between A. fumigatus and Other Pulmonary Pathogens
7. Conclusions
Author Contributions
Funding
Institutional Review Board Statement
Informed Consent Statement
Data Availability Statement
Acknowledgments
Conflicts of Interest
References
- Peters, B.M.; Jabra-rizk, M.A.; Costerton, J.W.; Shirtliff, M.E. Polymicrobial Interactions: Impact on Pathogenesis and Human Disease. Clin. Microbiol Rev. 2012, 12, 193–213. [Google Scholar] [CrossRef]
- Murray, J.L.; Connell, J.L.; Stacy, A.; Turner, K.H.; Whiteley, M. Mechanisms of synergy in polymicrobial infections. J. Microbiol. 2014, 52, 188–199. [Google Scholar] [CrossRef]
- Gabrilska, R.A.; Rumbaugh, K.P. Biofilm models of polymicrobial infection. Future Microbiol. 2015, 10, 1997–2015. [Google Scholar] [CrossRef]
- Yang, Y.; Hu, M.; Yu, K.; Zeng, X.; Liu, X. Mass spectrometry-based proteomic approaches to study pathogenic bacteria-host interactions. Protein Cell. 2015, 6, 265–274. [Google Scholar] [CrossRef] [PubMed]
- Darch, S.E.; Ibberson, C.B.; Whiteley, M. Evolution of Bacterial “Frenemies”. MBio 2017, 8. [Google Scholar] [CrossRef]
- Filkins, L.M.; O’Toole, G.A. Cystic Fibrosis Lung Infections: Polymicrobial, Complex, and Hard to Treat. PLoS Pathog. 2015, 11, e1005258. [Google Scholar] [CrossRef]
- Kosmidis, C.; Denning, D.W. The clinical spectrum of pulmonary aspergillosis. Postgrad. Med. J. 2015, 91, 403–410. [Google Scholar] [CrossRef]
- Latgé, J.P. Aspergillus fumigatus and Aspergillosis. Clin. Microbiol. Rev. 1999, 12, 310–350. [Google Scholar] [CrossRef] [PubMed]
- Paulussen, C.; Hallsworth, J.E.; Álvarez-Pérez, S.; Nierman, W.C.; Hamill, P.G.; Blain, D.; Rediers, H.; Lievens, B. Ecology of aspergillosis: Insights into the pathogenic potency of Aspergillus fumigatus and some other Aspergillus species. Microb. Biotechnol. 2017, 10, 296–322. [Google Scholar] [CrossRef]
- Chang, Y.C.; Tsai, H.-F.; Karos, M.; Kwon-Chung, K.J. THTA, a thermotolerance gene of Aspergillus fumigatus. Fungal Genet. Biol. 2004, 41, 888–896. [Google Scholar] [CrossRef]
- Bignell, E.; Negrete-Urtasun, S.; Calcagno, A.M.; Haynes, K.; Arst, H.N., Jr.; Rogers, T. The Aspergillus pH-responsive transcription factor PacC regulates virulence. Mol. Microbiol. 2005, 55, 1072–1084. [Google Scholar] [CrossRef] [PubMed]
- Bertuzzi, M.; Schrettl, M.; Alcazar-Fuoli, L.; Cairns, T.C.; Munoz, A.; Walker, L.A.; Herbst, S.; Safari, M.; Cheverton, A.M.; Chen, D.; et al. The pH-responsive PacC transcription factor of Aspergillus fumigatus governs epithelial entry and tissue invasion during pulmonary aspergillosis. PLoS Pathog. 2014, 10, e1004413. [Google Scholar] [CrossRef]
- Beauvais, A.; Schmidt, C.; Guadagnini, S.; Roux, P.; Perret, E.; Henry, C.; Paris, S.; Mallet, A.; Prévost, M.-C.; Latgé, J. An extracellular matrix glues together the aerial-grown hyphae of Aspergillus fumigatus. Cell. Microbiol. 2007, 9, 1588–1600. [Google Scholar] [CrossRef]
- Müller, F.-M.C.; Seidler, M.; Beauvais, A. Aspergillus fumigatus biofilms in the clinical setting. Med. Mycol. 2011, 49, S96–S100. [Google Scholar] [CrossRef]
- Mowat, E.; Williams, C.; Jones, B.; McChlery, S.; Ramage, G. The characteristics of Aspergillus fumigatus mycetoma development: Is this a biofilm? Med. Mycol. 2009, 47, S120–S126. [Google Scholar] [CrossRef]
- Mowat, E.; Rajendran, R.; Williams, C.; McCulloch, E.; Jones, B.; Lang, S.; Ramage, G. Pseudomonas aeruginosa and their small diffusible extracellular molecules inhibit Aspergillus fumigatus biofilm formation. FEMS Microbiol. Lett. 2010, 313, 96–102. [Google Scholar] [CrossRef] [PubMed]
- Manavathu, E.K.; Vager, D.L.; Vazquez, J.A. Development and antimicrobial susceptibility studies of in vitro monomicrobial and polymicrobial biofilm models with Aspergillus fumigatus and Pseudomonas aeruginosa. BMC Microbiol. 2014, 14, 53. [Google Scholar] [CrossRef] [PubMed]
- Ramírez Granillo, A.; Canales, M.G.M.; Espíndola, M.E.S.; Martínez Rivera, M.A.; de Lucio, V.M.B.; Tovar, A.V.R. Antibiosis interaction of Staphylococccus aureus on Aspergillus fumigatus assessed in vitro by mixed biofilm formation. BMC Microbiol. 2015, 15, 33. [Google Scholar] [CrossRef]
- De Jesus Carrion, S.; Leal, S.M., Jr.; Ghannoum, M.A.; Aimanianda, V.; Latgé, J.-P.; Pearlman, E. The RodA hydrophobin on Aspergillus fumigatus spores masks dectin-1- and dectin-2-dependent responses and enhances fungal survival in vivo. J. Immunol. 2013, 191, 2581–2588. [Google Scholar] [CrossRef]
- Margalit, A.; Kavanagh, K. The innate immune response to Aspergillus fumigatus at the alveolar surface. FEMS Microbiol. Rev. 2015, 39, 670–687. [Google Scholar] [CrossRef]
- Heinekamp, T.; Thywißen, A.; Macheleidt, J.; Keller, S.; Valiante, V.; Brakhage, A.A. Aspergillus fumigatus melanins: Interference with the host endocytosis pathway and impact on virulence. Front. Microbiol. 2013, 3, 440. [Google Scholar] [CrossRef] [PubMed]
- Jahn, B.; Langfelder, K.; Schneider, U.; Schindel, C.; Brakhage, A.A. PKSP-dependent reduction of phagolysosome fusion and intracellular kill of Aspergillus fumigatus conidia by human monocyte-derived macrophages. Cell. Microbiol. 2002, 4, 793–803. [Google Scholar] [CrossRef]
- Pal, A.K.; Gajjar, D.U.; Vasavada, A.R. DOPA and DHN pathway orchestrate melanin synthesis in Aspergillus species. Med. Mycol. 2013, 52, 10–18. [Google Scholar]
- Chabi, M.L.; Goracci, A.; Roche, N.; Paugam, A.; Lupo, A.; Revel, M.P. Pulmonary aspergillosis. Diagn. Interv. Imaging. 2015, 96, 435–442. [Google Scholar] [CrossRef]
- Hope, W.W.; Walsh, T.J.; Denning, D.W. The invasive and saprophytic syndromes due to Aspergillus spp. Med. Mycol. 2005, 43, S207–S238. [Google Scholar] [CrossRef]
- Stevens, D.A.; Moss, R.B.; Kurup, V.P.; Knutsen, A.P.; Greenberger, P.; Judson, M.A.; Denning, D.W.; Crameri, R.; Brody, A.S.; Light, M.; et al. Allergic bronchopulmonary aspergillosis in cystic fibrosis—state of the art: Cystic Fibrosis Foundation Consensus Conference. Clin. Infect. Dis. 2003, 37, S225–S264. [Google Scholar] [CrossRef]
- Janahi, I.A.; Rehman, A.; Al-Naimi, A.R. Allergic bronchopulmonary aspergillosis in patients with cystic fibrosis. Ann. Thorac. Med. 2017, 12, 74–82. [Google Scholar] [CrossRef]
- Patterson, K.; Strek, M.E. Allergic Bronchopulmonary Aspergillosis. Proc. Am. Thorac. Soc. 2010, 7, 237–244. [Google Scholar] [CrossRef]
- Tanner, N.T.; Judson, M.A. Diagnosis and treatment of allergic bronchopulmonary aspergillosis. Curr. Fungal Infect. Rep. 2008, 2, 199. [Google Scholar] [CrossRef]
- Knutsen, A.P.; Hutcheson, P.S.; Slavin, R.G.; Kurup, V.P. IgE antibody to Aspergillus fumigatus recombinant allergens in cystic fibrosis patients with allergic bronchopulmonary aspergillosis. Allergy 2004, 59, 198–203. [Google Scholar] [CrossRef] [PubMed]
- Agarwal, R.; Maskey, D.; Aggarwal, A.N.; Saikia, B.; Garg, M.; Gupta, D.; Chakrabarti, A. Diagnostic Performance of Various Tests and Criteria Employed in Allergic Bronchopulmonary Aspergillosis: A Latent Class Analysis. PLoS ONE 2013, 8, e61105. [Google Scholar] [CrossRef]
- Knutsen, A.P.; Slavin, R.G. Allergic bronchopulmonary aspergillosis in asthma and cystic fibrosis. Clin. Dev. Immunol. 2011. [Google Scholar] [CrossRef] [PubMed]
- Farnell, E.; Rousseau, K.; Thornton, D.J.; Bowyer, P.; Herrick, S.E. Expression and secretion of Aspergillus fumigatus proteases are regulated in response to different protein substrates. Fungal Biol. 2012, 116, 1003–1012. [Google Scholar] [CrossRef] [PubMed]
- Daly, P.; Kavanagh, K. Pulmonary aspergillosis: Clinical presentation, diagnosis and therapy. Br. J. Biomed. Sci. 2001, 58, 197–205. [Google Scholar]
- Kogan, T.V.; Jadoun, J.; Mittelman, L.; Hirschberg, K.; Osherov, N. Involvement of Secreted Aspergillus fumigatus Proteases in Disruption of the Actin Fiber Cytoskeleton and Loss of Focal Adhesion Sites in Infected A549 Lung Pneumocytes. J. Infect. Dis. 2004, 189, 1965–1973. [Google Scholar] [CrossRef]
- Amitani, R.; Taylor, G.; Elezis, E.N.; Llewellyn-Jones, C.; Mitchell, J.; Kuze, F.; Cole, P.J.; Wilson, R. Purification and characterization of factors produced by Aspergillus fumigatus which affect human ciliated respiratory epithelium. Infect. Immun. 1995, 63, 3266–3271. [Google Scholar] [CrossRef]
- Caminati, M.; Le Pham, D.; Bagnasco, D.; Canonica, G.W. Type 2 immunity in asthma. World Allergy Organ. J. 2018, 11, 13. [Google Scholar] [CrossRef]
- Zhu, Z.; Homer, R.J.; Wang, Z.; Chen, Q.; Geba, G.P.; Wang, J.; Zhang, Y.; Elias, J.A. Pulmonary expression of interleukin-13 causes inflammation, mucus hypersecretion, subepithelial fibrosis, physiologic abnormalities, and eotaxin production. J. Clin. Investig. 1999, 103, 779–788. [Google Scholar] [CrossRef] [PubMed]
- Fahy, J.V. Type 2 inflammation in asthma—present in most, absent in many. Nat. Rev. Immunol. 2015, 15, 57–65. [Google Scholar] [CrossRef]
- de Almeida, M.B.; Bussamra, M.H.F.; Rodrigues, J.C. Allergic bronchopulmonary aspergillosis in paediatric cystic fibrosis patients. Paediatr. Respir. Rev. 2006, 7, 67–72. [Google Scholar]
- Burgel, P.-R.; Paugam, A.; Hubert, D.; Martin, C. Aspergillus fumigatus in the cystic fibrosis lung: Pros and cons of azole therapy. Infect. Drug Resist. 2016, 9, 229–238. [Google Scholar] [CrossRef]
- Reece, E.; McClean, S.; Greally, P.; Renwick, J. The prevalence of Aspergillus fumigatus in early cystic fibrosis disease is underestimated by culture-based diagnostic methods. J. Microbiol. Methods 2019, 164, 105683. [Google Scholar] [CrossRef]
- Breuer, O.; Schultz, A.; Garratt, L.W.; Turkovic, L.; Rosenow, T.; Murray, C.P.; Karpievitch, Y.V.; Akesson, L.; Dalton, S.; Sly, P.D.; et al. Aspergillus Infections and Progression of Structural Lung Disease in Children with Cystic Fibrosis. Am. J. Respir. Crit. Care Med. 2019, 201, 688–696. [Google Scholar] [CrossRef]
- Breuer, O.; Schultz, A.; Turkovic, L.; de Klerk, N.; Keil, A.D.; Brennan, S.; Harrison, J.; Robertson, C.; Robinson, P.J.; Sly, P.D.; et al. Changing Prevalence of Lower Airway Infections in Young Children with Cystic Fibrosis. Am. J. Respir. Crit. Care Med. 2019, 200, 590–599. [Google Scholar] [CrossRef] [PubMed]
- Saunders, R.V.; Modha, D.E.; Claydon, A.; Gaillard, E.A. Chronic Aspergillus fumigatus colonization of the pediatric cystic fibrosis airway is common and may be associated with a more rapid decline in lung function. Med. Mycol. 2016, 54, 537–543. [Google Scholar] [CrossRef]
- Harun, S.N.; Wainwright, C.E.; Grimwood, K.; Hennig, S. Aspergillus and progression of lung disease in children with cystic fibrosis. Thorax 2019, 74, 125–131. [Google Scholar] [CrossRef] [PubMed]
- Reece, E.; Segurado, R.; Jackson, A.; McClean, S.; Renwick, J.; Greally, P. Co-colonisation with Aspergillus fumigatus and Pseudomonasa eruginosais associated with poorer health in cystic fibrosis patients: An Irish registry analysis. BMC Pulm. Med. 2017, 17, 1–8. [Google Scholar] [CrossRef] [PubMed]
- Stover, C.K.; Pham, X.Q.; Erwin, A.L.; Mizoguchi, S.D.; Warrener, P.; Hickey, M.J.; Brinkman, F.S.L.; Hufnagle, W.O.; Kowalik, D.J.; Lagrou, M.; et al. Complete genome sequence of Pseudomonas aeruginosa PAO1, an opportunistic pathogen. Nature 2000, 406, 959–964. [Google Scholar] [CrossRef] [PubMed]
- Greenberg, E.P. Pump up the versatility. Nature 2000, 406, 947–948. [Google Scholar] [CrossRef] [PubMed]
- Pang, Z.; Raudonis, R.; Glick, B.R.; Lin, T.-J.; Cheng, Z. Antibiotic resistance in Pseudomonas aeruginosa: Mechanisms and alternative therapeutic strategies. Biotechnol. Adv. 2019, 37, 177–192. [Google Scholar] [CrossRef] [PubMed]
- Jesaitis, A.J.; Franklin, M.J.; Berglund, D.; Sasaki, M.; Lord, C.I.; Bleazard, J.B.; Duffy, J.E.; Beyenal, H.; Lewandowski, Z. Compromised host defense on Pseudomonasaeruginosa biofilms: Characterization of neutrophil and biofilm interactions. J. Immunol. 2003, 171, 4329–4339. [Google Scholar] [CrossRef] [PubMed]
- Parsek, M.R.; Greenberg, E.P. Sociomicrobiology: The connections between quorum sensing and biofilms. Trends Microbiol. 2005, 13, 27–33. [Google Scholar] [CrossRef] [PubMed]
- Jensen, P.Ø.; Bjarnsholt, T.; Phipps, R.; Rasmussen, T.B.; Calum, H.; Christoffersen, L.; Moser, C.; Williams, P.; Pressler, T.; Givskov, M.; et al. Rapid necrotic killing of polymorphonuclear leukocytes is caused by quorum-sensing-controlled production of rhamnolipid by Pseudomonas aeruginosa. Microbiology 2007, 153, 1329–1338. [Google Scholar] [CrossRef]
- Managò, A.; Becker, K.A.; Carpinteiro, A.; Wilker, B.; Soddemann, M.; Seitz, A.P.; Edwards, M.J.; Grassmé, H.; Szabò, I.; Gulbins, E. Pseudomonas aeruginosa Pyocyanin Induces Neutrophil Death via Mitochondrial Reactive Oxygen Species and Mitochondrial Acid Sphingomyelinase. Antioxid. Redox Signal. 2015, 22, 1097–1110. [Google Scholar]
- Singh, P.K.; Parsek, M.R.; Greenberg, E.P.; Welsh, M.J. A component of innate immunity prevents bacterial biofilm development. Nature 2002, 417, 552–555. [Google Scholar] [CrossRef]
- Stintzi, A.; Evans, K.; Meyer, J.M.; Poole, K. Quorum-sensing and siderophore biosynthesis in Pseudomonas aeruginosa: lasR/lasI mutants exhibit reduced pyoverdine biosynthesis. FEMS Microbiol. Lett. 1998, 166, 341–345. [Google Scholar] [CrossRef]
- Marvig, R.L.; Sommer, L.M.; Molin, S.; Johansen, H.K. Convergent evolution and adaptation of Pseudomonas aeruginosa within patients with cystic fibrosis. Nat. Genet. 2014, 47, 57. [Google Scholar] [CrossRef] [PubMed]
- Mauch, R.M.; Jensen, P.O.; Moser, C.; Levy, C.E.; Hoiby, N. Mechanisms of humoral immune response against Pseudomonas aeruginosa biofilm infection in cystic fibrosis. J. Cyst. Fibros. 2018, 17, 143–152. [Google Scholar] [CrossRef]
- Wolfgang, M.C.; Jyot, J.; Goodman, A.L.; Ramphal, R.; Lory, S. Pseudomonas aeruginosa regulates flagellin expression as part of a global response to airway fluid from cystic fibrosis patients. Proc. Natl. Acad. Sci. USA 2004, 101, 6664–6668. [Google Scholar] [CrossRef] [PubMed]
- Hoffman, L.R.; Kulasekara, H.D.; Emerson, J.; Houston, L.S.; Burns, J.L.; Ramsey, B.W.; Miller, S.I. Pseudomonas aeruginosa lasR mutants are associated with cystic fibrosis lung disease progression. J. Cyst. Fibros. 2009, 8, 66–70. [Google Scholar] [CrossRef]
- Jain, M.; Ramirez, D.; Seshadri, R.; Cullina, J.F.; Powers, C.A.; Schulert, G.S.; Bar-Meir, M.; Sullivan, C.L.; McColley, S.A.; Hauser, A.R. Type III secretion phenotypes of Pseudomonas aeruginosa strains change during infection of individuals with cystic fibrosis. J. Clin. Microbiol. 2004, 42, 5229–5237. [Google Scholar] [CrossRef] [PubMed]
- Filkins, L.M.; Hampton, T.H.; Gifford, A.H.; Gross, M.J.; Hogan, D.A.; Sogin, M.L.; Morrison, H.G.; Paster, B.J.; O’Toole, G.A. Prevalence of streptococci and increased polymicrobial diversity associated with cystic fibrosis patient stability. J. Bacteriol. 2012, 194, 4709–4717. [Google Scholar] [CrossRef] [PubMed]
- Harrison, F. Microbial ecology of the cystic fibrosis lung. Microbiology 2007, 153, 917–923. [Google Scholar] [CrossRef] [PubMed]
- The Cystic Fibriosis Registry of Ireland. CF Registry of Ireland 2017 Annual Report; The Cystic Fibriosis Registry of Ireland: Dublin, Ireland, 2017; p. 47. [Google Scholar]
- Zemanick, E.T.; Wagner, B.D.; Robertson, C.E.; Ahrens, R.C.; Chmiel, J.F.; Clancy, J.P.; Gibson, R.L.; Harris, W.T.; Kurland, G.; Laguna, T.A.; et al. Airway microbiota across age and disease spectrum in cystic fibrosis. Eur. Respir. J. 2017, 50, 1–13. [Google Scholar] [CrossRef] [PubMed]
- Coburn, B.; Wang, P.W.; Caballero, J.D.; Clark, S.T.; Brahma, V.; Donaldson, S.; Zhang, Y.; Surendra, A.; Gong, Y.; Tullis, D.E.; et al. Lung microbiota across age and disease stage in cystic fibrosis. Sci. Rep. 2015, 5, 10241. [Google Scholar] [CrossRef] [PubMed]
- Cystic Fibrosis Foundation Patient Registry. 2017 Annual Data Report; Cystic Fibrosis Foundation Patient Registry: Bethesda, MD, USA, 2018. [Google Scholar]
- Cystic Fibrosis Trust. UK Cystic Fibrosis Registry Annual Data Report; Cystic Fibrosis Trust: London, UK, 2017. [Google Scholar]
- Riley, T.V.; Hoffman, D.C. Interference with Haemophilus influenzae growth by other microorganisms. FEMS Microbiol. Lett. 1986, 33, 55–58. [Google Scholar] [CrossRef]
- Baldan, R.; Cigana, C.; Testa, F.; Bianconi, I.; De Simone, M.; Pellin, D.; Di Serio, C.; Bragonzi, A.; Cirillo, D.M. Adaptation of Pseudomonas aeruginosa in Cystic Fibrosis Airways Influences Virulence of Staphylococcus aureus in vitro and Murine Models of Co-Infection. PLoS ONE 2014, 9, e89614. [Google Scholar] [CrossRef]
- Purcell, P.; Jary, H.; Perry, A.; Perry, J.D.; Stewart, C.J.; Nelson, A.; Lanyon, C.; Smith, D.L.; Cummings, S.P.; De Soyza, A. Polymicrobial airway bacterial communities in adult bronchiectasis patients. BMC Microbiol. 2014, 14, 130. [Google Scholar] [CrossRef]
- Woo, T.E.; Lim, R.; Heirali, A.A.; Acosta, N.; Rabin, H.R.; Mody, C.H.; Somayaji, R.; Surette, M.G.; Sibley, C.D.; Storey, D.G.; et al. A longitudinal characterization of the Non-Cystic Fibrosis Bronchiectasis airway microbiome. Sci. Rep. 2019, 9, 6871. [Google Scholar] [CrossRef]
- Gallego, M.; Pomares, X.; Espasa, M.; Castañer, E.; Solé, M.; Suárez, D.; Monsó, E.; Montón, C. Pseudomonas aeruginosa isolates in severe chronic obstructive pulmonary disease: Characterization and risk factors. BMC Pulm. Med. 2014, 14, 103. [Google Scholar] [CrossRef]
- Murphy, T.F.; Brauer, A.L.; Eschberger, K.; Lobbins, P.; Grove, L.; Cai, X.; Sethi, S. Pseudomonas aeruginosa in chronic obstructive pulmonary disease. Am. J. Respir. Crit. Care Med. 2008, 177, 853–860. [Google Scholar] [CrossRef] [PubMed]
- Araújo, D.; Shteinberg, M.; Aliberti, S.; Goeminne, P.C.; Hill, A.T.; Fardon, T.C.; Obradovic, D.; Stone, G.; Trautmann, M.; Davis, A.; et al. The independent contribution of Pseudomonas aeruginosa infection to long-term clinical outcomes in bronchiectasis. Eur. Respir. J. 2018, 51. [Google Scholar] [CrossRef] [PubMed]
- Chai, Y.-H.; Xu, J.-F. How does Pseudomonas aeruginosa affect the progression of bronchiectasis? Clin. Microbiol. Infect. 2020, 26, 313–318. [Google Scholar] [CrossRef] [PubMed]
- McDonnell, M.J.; Jary, H.R.; Perry, A.; MacFarlane, J.G.; Hester, K.L.M.; Small, T.; Molyneux, C.; Perry, J.D.; Walton, K.E.; De Soyza, A. Non cystic fibrosis bronchiectasis: A longitudinal retrospective observational cohort study of Pseudomonas persistence and resistance. Respir. Med. 2015, 109, 716–726. [Google Scholar] [CrossRef]
- Kaur, J.; Pethani, B.P.; Kumar, S.; Kim, M.; Sunna, A.; Kautto, L.; Penesyan, A.; Paulsen, I.T.; Nevalainen, H. Pseudomonas aeruginosa inhibits the growth of Scedosporium aurantiacum, an opportunistic fungal pathogen isolated from the lungs of cystic fibrosis patients. Front. Microbiol. 2015, 6, 866. [Google Scholar] [CrossRef]
- Bandara, H.M.H.N.; Yau, J.Y.Y.; Watt, R.M.; Jin, L.J.; Samaranayake, L.P. Pseudomonas aeruginosa inhibits in vitro Candida biofilm development. BMC Microbiol. 2010, 10, 125. [Google Scholar] [CrossRef]
- Rella, A.; Yang, M.W.; Gruber, J.; Montagna, M.T.; Luberto, C.; Zhang, Y.-M.; Del Poeta, M. Pseudomonas aeruginosa inhibits the growth of Cryptococcus species. Mycopathologia 2012, 173, 451–461. [Google Scholar] [CrossRef]
- Zhao, J.; Cheng, W.; He, X.; Liu, Y. The co-colonization prevalence of Pseudomonas aeruginosa and Aspergillus fumigatus in cystic fibrosis: A systematic review and meta-analysis. Microb. Pathog. 2018, 125, 122–128. [Google Scholar] [CrossRef]
- Paugam, A.; Baixench, M.-T.; Demazes-Dufeu, N.; Burgel, P.-R.; Sauter, E.; Kanaan, R.; Dusser, D.; Dupouy-Camet, J.; Hubert, D. Characteristics and consequences of airway colonization by filamentous fungi in 201 adult patients with cystic fibrosis in France. Med. Mycol. 2010, 48, S32–S36. [Google Scholar] [CrossRef]
- Hector, A.; Kirn, T.; Ralhan, A.; Graepler-Mainka, U.; Berenbrinker, S.; Riethmueller, J.; Hogardt, M.; Wagner, M.; Pfleger, A.; Autenrieth, I.; et al. Microbial colonization and lung function in adolescents with cystic fibrosis. J. Cyst. Fibros. 2016, 15, 340–349. [Google Scholar] [CrossRef]
- Huerta, A.; Soler, N.; Esperatti, M.; Guerrero, M.; Menendez, R.; Gimeno, A.; Zalacaín, R.; Mir, N.; Aguado, J.M.; Torres, A. Importance of Aspergillus spp. isolation in Acute exacerbations of severe COPD: Prevalence, factors and follow-up: The Fungi-COPD study. Respir. Res. 2014, 15, 17. [Google Scholar] [CrossRef]
- Everaerts, S.; Lagrou, K.; Vermeersch, K.; Dupont, L.J.; Vanaudenaerde, B.M.; Janssens, W. Aspergillus fumigatus Detection and Risk Factors in Patients with COPD-Bronchiectasis Overlap. Int. J. Mol. Sci. 2018, 19, 523. [Google Scholar] [CrossRef]
- Máiz, L.; Nieto, R.; Cantón, R.; Gómez de la Pedrosa, E.; Martinez-García, M.Á. Fungi in Bronchiectasis: A Concise Review. Int. J. Mol. Sci. 2018, 19, 142. [Google Scholar] [CrossRef]
- Moss, R.B. Fungi in cystic fibrosis and non-cystic fibrosis bronchiectasis. Semin. Respir. Crit. Care Med. 2015, 36, 207–216. [Google Scholar] [CrossRef]
- Everaerts, S.; Lagrou, K.; Dubbeldam, A.; Lorent, N.; Vermeersch, K.; Van Hoeyveld, E.; Bossuyt, X.; Dupont, L.J.; Vanaudenaerde, B.M.; Janssens, W. Sensitization to Aspergillus fumigatus as a risk factor for bronchiectasis in COPD. Int. J. Chron. Obstruct. Pulmon. Dis. 2017, 12, 2629–2638. [Google Scholar] [CrossRef]
- Bilton, D. Update on non-cystic fibrosis bronchiectasis. Curr. Opin. Pulm. Med. 2008, 14, 595–599. [Google Scholar] [CrossRef] [PubMed]
- Williams, C.; Ranjendran, R.; Ramage, G. Pathogenesis of Fungal Infections in Cystic Fibrosis. Curr. Fungal Infect. Rep. 2016, 10, 163–169. [Google Scholar] [CrossRef] [PubMed]
- Briard, B.; Mislin, G.L.A.; Latgé, J.-P.; Beauvais, A. Interactions between Aspergillus fumigatus and Pulmonary Bacteria: Current State of the Field, New Data, and Future Perspective. J. Fungi (Basel, Switzerland) 2019, 5, 48. [Google Scholar] [CrossRef] [PubMed]
- O’Brien, S.; Fothergill, J.L. The role of multispecies social interactions in shaping Pseudomonas aeruginosa pathogenicity in the cystic fibrosis lung. FEMS Microbiol. Lett. 2017, 364, fnx128. [Google Scholar] [CrossRef] [PubMed]
- Smith, E.E.; Buckley, D.G.; Wu, Z.; Saenphimmachak, C.; Hoffman, L.R.; D’Argenio, D.A.; Miller, S.I.; Ramsey, B.W.; Speert, D.P.; Moskowitz, S.M.; et al. Genetic adaptation by Pseudomonas aeruginosa to the airways of cystic fibrosis patients. Proc. Natl. Acad. Sci. USA 2006, 103, 8487–8492. [Google Scholar] [CrossRef]
- Sass, G.; Nazik, H.; Penner, J.; Shah, H.; Ansari, S.R.; Clemons, K.; Groleau, M.-C.; Dietl, A.-M.; Visca, P.; Haas, H.; et al. Studies of Pseudomonas aeruginosa Mutants Indicate Pyoverdine as the Central Factor in Inhibition of Aspergillus fumigatus Biofilm. J. Bacteriol. 2018, 200, 1–24. [Google Scholar]
- Briard, B.; Bomme, P.; Lechner, B.E.; Mislin, G.L.A.; Lair, V.; Prévost, M.C.; Latgé, J.P.; Haas, H.; Beauvais, A. Pseudomonas aeruginosa manipulates redox and iron homeostasis of its microbiota partner Aspergillus fumigatus via phenazines. Sci. Rep. 2015, 5, 8220. [Google Scholar] [CrossRef] [PubMed]
- Shirazi, F.; Ferreira, J.A.G.; Stevens, D.A.; Clemons, K.V.; Kontoyiannis, D.P. Biofilm filtrates of Pseudomonas aeruginosa strains isolated from cystic fibrosis patients inhibit preformed Aspergillus fumigatus biofilms via apoptosis. PLoS ONE 2016, 11, e0150155. [Google Scholar] [CrossRef]
- Ferreira, J.A.G.; Penner, J.C.; Moss, R.B.; Haagensen, J.A.J.; Clemons, K.V.; Spormann, A.M.; Nazik, H.; Cohen, K.; Banaei, N.; Carolino, E.; et al. Inhibition of Aspergillus fumigatus and Its Biofilm by Pseudomonas aeruginosa Is Dependent on the Source, Phenotype and Growth Conditions of the Bacterium. PLoS ONE 2015, 10, e0134692. [Google Scholar] [CrossRef]
- Bargon, J.; Dauletbaev, N.; Köhler, B.; Wolf, M.; Posselt, H.-G.; Wagner, T.O.F. Prophylactic antibiotic therapy is associated with an increased prevalence of Aspergillus colonization in adult cystic fibrosis patients. Respir. Med. 1999, 93, 835–838. [Google Scholar] [CrossRef]
- Aaron, S.D.; Vandemheen, K.L.; Freitag, A.; Pedder, L.; Cameron, W.; Lavoie, A.; Paterson, N.; Wilcox, P.; Rabin, H.; Tullis, E.; et al. Treatment of Aspergillus fumigatus in Patients with Cystic Fibrosis: A Randomized, Placebo-Controlled Pilot Study. PLoS ONE 2012, 7, e36077. [Google Scholar] [CrossRef] [PubMed]
- Reece, E.; Doyle, S.; Greally, P.; Renwick, J.; McClean, S. Aspergillus fumigatus inhibits Pseudomonas aeruginosa in co-culture: Implications of a mutually antagonistic relationship on virulence and inflammation in the CF airway. Front. Microbiol. 2018, 9, 1–14. [Google Scholar] [CrossRef] [PubMed]
- Briard, B.; Heddergott, C.; Latgé, J. Volatile compounds emitted by pseudomonas aeruginosa stimulate growth of the fungal pathogen Aspergillus fumigatus. MBio 2016, 7, 1–5. [Google Scholar] [CrossRef] [PubMed]
- Briard, B.; Rasoldier, V.; Bomme, P.; El Aouad, N.; Guerreiro, C.; Chassagne, P.; Muszkieta, L.; Latge, J.-P.; Mulard, L.; Beauvais, A. Dirhamnolipids secreted from Pseudomonas aeruginosa modify fungal susceptibility of Aspergillus fumigatus by inhibiting beta1,3 glucan synthase activity. ISME J. 2017, 11, 1578–1591. [Google Scholar] [CrossRef] [PubMed]
- Price-Whelan, A.; Dietrich, L.E.P.; Newman, D.K. Rethinking “secondary” metabolism: Physiological roles for phenazine antibiotics. Nat. Chem. Biol. 2006, 2, 71–78. [Google Scholar] [CrossRef]
- Price, C.E.; Brown, D.G.; Limoli, D.H.; Phelan, V.V.; O’Toole, G.A. Exogenous alginate protects Staphylococcus aureus from killing by Pseudomonas aeruginosa. J. Bacteriol 2020, 202, e00559-19. [Google Scholar] [CrossRef]
- Smith, K.; Rajendran, R.; Kerr, S.; Lappin, D.F.; Mackay, W.G.; Williams, C.; Ramage, G. Aspergillus fumigatus enhances elastase production in Pseudomonas aeruginosa co-cultures. Med. Mycol. 2015, 53, 645–655. [Google Scholar] [CrossRef] [PubMed]
- Eisenman, H.C.; Casadevall, A. Synthesis and assembly of fungal melanin. Appl. Microbiol. Biotechnol. 2012, 93, 931–940. [Google Scholar] [CrossRef]
- Kuang, Z.; Hao, Y.; Walling, B.E.; Jeffries, J.L.; Ohman, D.E.; Lau, G.W. Pseudomonas aeruginosa Elastase Provides an Escape from Phagocytosis by Degrading the Pulmonary Surfactant Protein-A. PLoS ONE 2011, 6, e27091. [Google Scholar] [CrossRef] [PubMed]
- Nomura, K.; Obata, K.; Keira, T.; Miyata, R.; Hirakawa, S.; Takano, K.; Kohno, T.; Sawada, N.; Himi, T.; Kojima, T. Pseudomonas aeruginosa elastase causes transient disruption of tight junctions and downregulation of PAR-2 in human nasal epithelial cells. Respir. Res. 2014, 15, 21. [Google Scholar] [CrossRef] [PubMed]
- Mariencheck, W.I.; Alcorn, J.F.; Palmer, S.M.; Wright, J.R. Pseudomonas aeruginosa elastase degrades surfactant proteins A and D. Am. J. Respir. Cell Mol. Biol. 2003, 28, 528–537. [Google Scholar] [CrossRef]
- Rada, B.; Leto, T.L. Pyocyanin effects on respiratory epithelium: Relevance in Pseudomonas aeruginosa airway infections. Trends Microbiol. 2013, 21, 73–81. [Google Scholar] [CrossRef]
- Denning, G.M.; Iyer, S.S.; Reszka, K.J.; O’Malley, Y.; Rasmussen, G.T.; Britigan, B.E. Phenazine-1-carboxylic acid, a secondary metabolite of Pseudomonas aeruginosa, alters expression of immunomodulatory proteins by human airway epithelial cells. Am. J. Physiol. Lung Cell. Mol. Physiol. 2003, 285, L584–L592. [Google Scholar] [CrossRef]
- Sass, G.; Ansari, S.R.; Dietl, A.M.; Déziel, E.; Haas, H.; Stevens, D.A. Intermicrobial interaction: Aspergillus fumigatus siderophores protect against competition by Pseudomonas aeruginosa. PLoS ONE 2019, 14, e0216085. [Google Scholar] [CrossRef]
- Margalit, A.; Carolan, J.C.; Sheehan, D.; Kavanagh, K. The Aspergillus fumigatus Secretome Alters the Proteome of Pseudomonas aeruginosa to Stimulate Bacterial Growth: Implications for Co-infection. Mol. Cell. Proteom. 2020, 19, 1346–1359. [Google Scholar] [CrossRef]
- de Vries, R.P.; Visser, J. Aspergillus Enzymes Involved in Degradation of Plant Cell Wall Polysaccharides. Microbiol. Mol. Biol. Rev. 2001, 65, 497–522. [Google Scholar] [CrossRef]
- Wang, D.; Zhang, L.; Zou, H.; Wang, L. Secretome profiling reveals temperature-dependent growth of Aspergillus fumigatus. Sci. China Life Sci. 2018, 61, 578–592. [Google Scholar] [CrossRef]
- Tekaia, F.; Latge, J.-P. Aspergillus fumigatus: Saprophyte or pathogen? Curr. Opin. Microbiol. 2005, 8, 385–392. [Google Scholar] [CrossRef] [PubMed]
- Vivek-Ananth, R.P.; Mohanraj, K.; Vandanashree, M.; Jhingran, A.; Craig, J.P.; Samal, A. Comparative systems analysis of the secretome of the opportunistic pathogen Aspergillus fumigatus and other Aspergillus species. Sci. Rep. 2018, 8, 6617. [Google Scholar] [CrossRef] [PubMed]
- Wartenberg, D.; Lapp, K.; Jacobsen, I.D.; Dahse, H.-M.; Kniemeyer, O.; Heinekamp, T.; Brakhage, A.A. Secretome analysis of Aspergillus fumigatus reveals Asp-hemolysin as a major secreted protein. Int. J. Med. Microbiol. 2011, 301, 602–611. [Google Scholar] [CrossRef]
- Behnsen, J.; Lessing, F.; Schindler, S.; Wartenberg, D.; Jacobsen, I.D.; Thoen, M.; Zipfel, P.F.; Brakhage, A.A. Secreted Aspergillus fumigatus protease Alp1 degrades human complement proteins C3, C4, and C5. Infect. Immun. 2010, 78, 3585–3594. [Google Scholar] [CrossRef]
- Margalit, A.; Kavanagh, K.; Carolan, J.C. Characterization of the Proteomic Response of A549 Cells Following Sequential Exposure to Aspergillus fumigatus and Pseudomonas aeruginosa. J. Proteome Res. 2020, 19, 279–291. [Google Scholar] [CrossRef] [PubMed]
- Berkova, N.; Lair-Fulleringer, S.; Féménia, F.; Huet, D.; Wagner, M.C.; Gorna, K.; Tournier, F.; Ibrahim-Granet, O.; Guillot, J.; Chermette, R.; et al. Aspergillus fumigatus conidia inhibit tumour necrosis factor- or staurosporine-induced apoptosis in epithelial cells. Int. Immunol. 2006, 18, 139–150. [Google Scholar] [CrossRef][Green Version]
- Daly, P.; Verhaegen, S.; Clynes, M.; Kavanagh, K. Culture filtrates of Aspergillus fumigatus induce different modes of cell death in human cancer cell lines. Mycopathologia 1999, 146, 67–74. [Google Scholar] [CrossRef]
- Féménia, F.; Huet, D.; Lair-Fulleringer, S.; Wagner, M.C.; Sarfati, J.; Shingarova, L.; Guillot, J.; Boireau, P.; Chermette, R.; Berkova, N. Effects of Conidia of Various Aspergillus Species on Apoptosis of Human Pneumocytes and Bronchial Epithelial Cells. Mycopathologia 2009, 167, 249. [Google Scholar] [CrossRef]
- Scott, J.; Sueiro-Olivares, M.; Ahmed, W.; Heddergott, C.; Zhao, C.; Thomas, R.; Bromley, M.; Latgé, J.-P.; Krappmann, S.; Fowler, S.; et al. Pseudomonas aeruginosa-Derived Volatile Sulfur Compounds Promote Distal Aspergillus fumigatus Growth and a Synergistic Pathogen-Pathogen Interaction That Increases Pathogenicity in Co-infection. Front. Microbiol. 2019, 10, 2311. [Google Scholar] [CrossRef]
- Nasir, M.; Bean, H.D.; Smolinska, A.; Rees, C.A.; Zemanick, E.T.; Hill, J.E. Volatile molecules from bronchoalveolar lavage fluid can “rule-in” Pseudomonas aeruginosa and “rule-out” Staphylococcus aureus infections in cystic fibrosis patients. Sci. Rep. 2018, 8, 826. [Google Scholar] [CrossRef]
- Hurley, M.N. Staphylococcus aureus in cystic fibrosis: Problem bug or an innocent bystander? Breathe (Sheffield, England) 2018, 14, 87–90. [Google Scholar] [CrossRef]
- Delfino, E.; Del Puente, F.; Briano, F.; Sepulcri, C.; Giacobbe, D.R. Respiratory Fungal Diseases in Adult Patients with Cystic Fibrosis. Clin. Med. Insights. Circ. Respir. Pulm. Med. 2019, 13, 1179548419849939. [Google Scholar] [CrossRef] [PubMed]
- Askim, Å.; Mehl, A.; Paulsen, J.; DeWan, A.T.; Vestrheim, D.F.; Åsvold, B.O.; Damås, J.K.; Solligård, E. Epidemiology and outcome of sepsis in adult patients with Streptococcus pneumoniae infection in a Norwegian county 1993–2011: An observational study. BMC Infect. Dis. 2016, 16, 223. [Google Scholar] [CrossRef]
- Ostapchuk, M.; Roberts, D.M.; Haddy, R. Community-acquired pneumonia in infants and children. Am. Fam. Physician 2004, 70, 899–908. [Google Scholar]
- Asner, S.A.; Agyeman, P.K.A.; Gradoux, E.; Posfay-Barbe, K.M.; Heininger, U.; Giannoni, E.; Crisinel, P.A.; Stocker, M.; Bernhard-Stirnemann, S.; Niederer-Loher, A.; et al. Burden of Streptococcus pneumoniae Sepsis in Children After Introduction of Pneumococcal Conjugate Vaccines: A Prospective Population-based Cohort Study. Clin. Infect. Dis. 2019, 69, 1574–1580. [Google Scholar] [CrossRef] [PubMed]
- Bhatt, J.M. Treatment of pulmonary exacerbations in cystic fibrosis. Eur. Respir. Rev. 2013, 22, 205–216. [Google Scholar] [CrossRef]
- Maeda, Y.; Elborn, J.S.; Parkins, M.D.; Reihill, J.; Goldsmith, C.E.; Coulter, W.A.; Mason, C.; Millar, B.C.; Dooley, J.S.G.; Lowery, C.J.; et al. Population structure and characterization of viridans group streptococci (VGS) including Streptococcus pneumoniae isolated from adult patients with cystic fibrosis (CF). J. Cyst. Fibros. 2011, 10, 133–139. [Google Scholar] [CrossRef] [PubMed]
- Paganin, P.; Fiscarelli, E.V.; Tuccio, V.; Chiancianesi, M.; Bacci, G.; Morelli, P.; Dolce, D.; Dalmastri, C.; De Alessandri, A.; Lucidi, V.; et al. Changes in Cystic Fibrosis Airway Microbial Community Associated with a Severe Decline in Lung Function. PLoS ONE 2015, 10, e0124348. [Google Scholar] [CrossRef]
- Iwahashi, J.; Kamei, K.; Watanabe, H. Disruption of Aspergillus fumigatus biofilm by Streptococcus pneumoniae: Mycelial fragmentation by hydrogen peroxide. J. Infect. Chemother. 2020, 26, 831–837. [Google Scholar] [CrossRef]
- LiPuma, J.J. The Changing Microbial Epidemiology in Cystic Fibrosis. Clin. Microbiol. Rev. 2010, 23, 299–323. [Google Scholar] [CrossRef]
- Leão, R.S.; Pereira, R.H.V.; Folescu, T.W.; Albano, R.M.; Santos, E.A.; Junior, L.G.C.; Marques, E.A. KPC-2 Carbapenemase-producing Klebsiella pneumoniae isolates from patients with Cystic Fibrosis. J. Cyst. Fibros. 2011, 10, 140–142. [Google Scholar] [CrossRef] [PubMed]
- Nogueira, M.F.; Pereira, L.; Jenull, S.; Kuchler, K.; Lion, T. Klebsiella pneumoniae prevents spore germination and hyphal development of Aspergillus species. Sci. Rep. 2019, 9, 218. [Google Scholar] [CrossRef] [PubMed]
- Esposito, A.; Pompilio, A.; Bettua, C.; Crocetta, V.; Giacobazzi, E.; Fiscarelli, E.; Jousson, O.; Di Bonaventura, G. Evolution of Stenotrophomonas maltophilia in Cystic Fibrosis Lung over Chronic Infection: A Genomic and Phenotypic Population Study. Front. Microbiol. 2017, 8, 1590. [Google Scholar] [CrossRef] [PubMed]
- Hartl, D. Immunological mechanisms behind the cystic fibrosis-ABPA link. Med. Mycol. 2009, 47, S183–S191. [Google Scholar] [CrossRef]
- Ghosh, S.; Hoselton, S.A.; Schuh, J.M. Allergic Inflammation in Aspergillus fumigatus-Induced Fungal Asthma. Curr. Allergy Asthma Rep. 2015, 15, 59. [Google Scholar] [CrossRef]

Publisher’s Note: MDPI stays neutral with regard to jurisdictional claims in published maps and institutional affiliations. |
© 2021 by the authors. Licensee MDPI, Basel, Switzerland. This article is an open access article distributed under the terms and conditions of the Creative Commons Attribution (CC BY) license (http://creativecommons.org/licenses/by/4.0/).
Share and Cite
Margalit, A.; Carolan, J.C.; Kavanagh, K. Bacterial Interactions with Aspergillus fumigatus in the Immunocompromised Lung. Microorganisms 2021, 9, 435. https://doi.org/10.3390/microorganisms9020435
Margalit A, Carolan JC, Kavanagh K. Bacterial Interactions with Aspergillus fumigatus in the Immunocompromised Lung. Microorganisms. 2021; 9(2):435. https://doi.org/10.3390/microorganisms9020435
Chicago/Turabian StyleMargalit, Anatte, James C. Carolan, and Kevin Kavanagh. 2021. "Bacterial Interactions with Aspergillus fumigatus in the Immunocompromised Lung" Microorganisms 9, no. 2: 435. https://doi.org/10.3390/microorganisms9020435
APA StyleMargalit, A., Carolan, J. C., & Kavanagh, K. (2021). Bacterial Interactions with Aspergillus fumigatus in the Immunocompromised Lung. Microorganisms, 9(2), 435. https://doi.org/10.3390/microorganisms9020435
